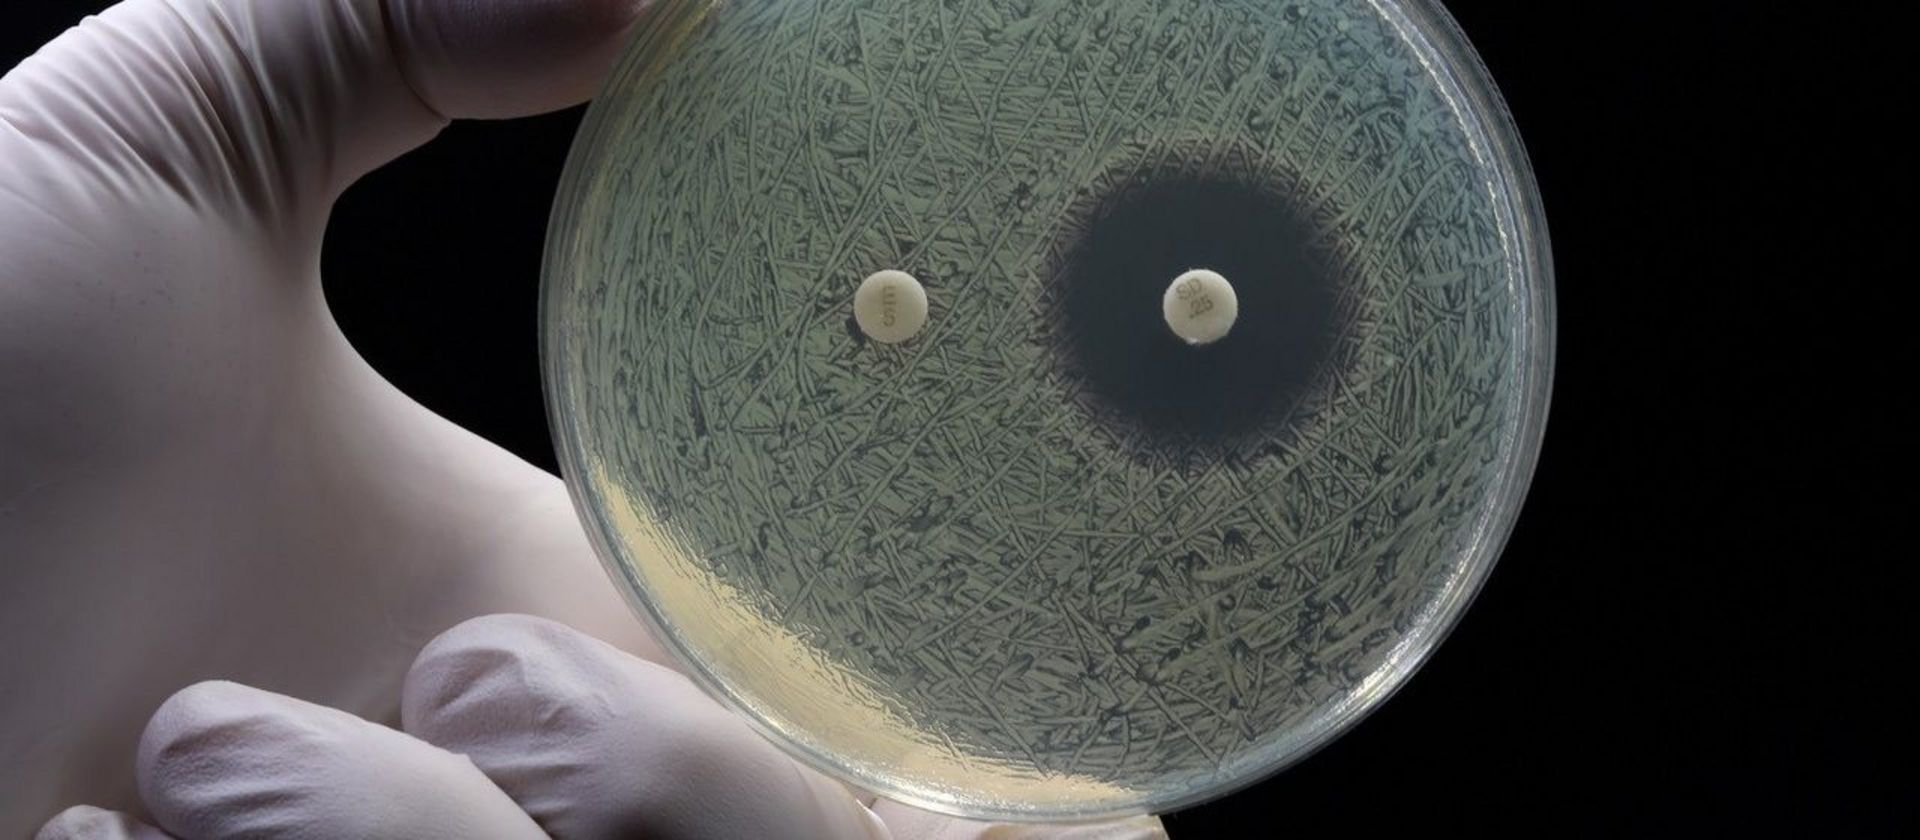

Saarbrücken, 2. September 2024 - Das Antibiotikum Odilorhabdin hat das Potenzial für den Einsatz gegen resistente Bakterien. Allerdings ist die Ausbeute der Produktion in Bakterien noch viel zu gering. Mithilfe des sogenannten NRPS-Engineering klärten Wissenschaftlerinnen und Wissenschaftler des Helmholtz-Instituts für Pharmazeutische Forschung Saarland (HIPS) in Kooperation mit dem Max-Planck-Institut für terrestrische Mikrobiologie in Marburg den Biosyntheseweg auf und zeigen Wege auf, die es künftig erlauben könnten, das Antibiotikum auf synthetisch-biologische Weise zu produzieren. Die Resultate leisten einen Beitrag zur beschleunigten Entwicklung wirksamer Antibiotika angesichts zunehmender bakterieller Resistenzen.
Das erst vor wenigen Jahren entdeckte Peptid-Antibiotikum Odilorhabdin wirkt gegen zahlreiche Bakterienarten, darunter auch solche, die gegen andere Antibiotika resistent sind. Damit ist Odilorhabdin ein vielversprechender Kandidat für eine neue Klasse zukünftiger Medikamente. Doch der Weg vom potenziellen Wirkstoff zum Medikament ist nicht einfach. Häufig produzieren die Bakterien als natürliche Produzenten die gewünschte Substanz nur in sehr geringen Mengen. Auch im Falle des Odilorhabdins ist die Ausbeute bei der Produktion durch Mikroorganismen noch viel zu gering, so dass eine ausgiebige Analyse der Entstehungsweise des Antibiotikums bislang nicht durchführbar schien.
Kürzlich gelang es Forschenden der Abteilung Mikrobielle Naturstoffe von Prof. Rolf Müller am HIPS in Kooperation mit Forschenden um Prof. Helge Bode vom Max-Planck-Institut für terrestrische Mikrobiologie in Marburg und der französischen Biotechnologie-Firma Nosopharm, die Bildung des Antibiotikums vollständig aufzuklären.
Der Schlüssel dazu war das sogenannte NRPS Engineering: Bei dieser Technik verändert man die genetischen Baupläne für nicht-ribosomale Peptidsynthetasen (kurz NRPS) – riesige bakterielle Enzyme in Bakterien und Pilzen, die einige der wichtigsten klinisch genutzten Antibiotika wie Penicillin und andere therapeutische Wirkstoffe produzieren. Es entstehen Enzyme mit neuen Fähigkeiten, die wiederum veränderte Antibiotika bilden.
Für diese Techniken war Odilorhabdin, wie viele andere sogenannte Peptid-Antibiotika, bislang schwer erfassbar. „Wir haben den genetischen Bauplan von Odilorhabdin, das sogenannte NRPS Gencluster, aus dem ursprünglichen Produzenten Xenorhabdus nematophila detailliert analysiert und modifiziert. Anschließend haben wir den neuen Bauplan in einen mikrobiellen Produzenten übertragen, der sich im Labor einfach kultivieren lässt“, erklärt Dr. Carsten Seyfert, Wissenschaftler in der Abteilung Mikrobielle Naturstoffe am HIPS. „Obwohl die Produktion im Bakterium E. coli aufgrund der Eigentoxizität von Odilorhabdin zunächst nicht optimal verlief, fanden wir in Zusammenarbeit mit dem Team von Helge Bode einen innovativen Weg, das Gencluster dennoch erfolgreich zu erforschen.“
Der Trick: Die Forschenden nahmen sich das Antibiotikum stückweise vor und koppelten seine Teile an bekannte Biosynthesegene, um so die jeweiligen Funktionen der einzelnen Abschnitte mit Hilfe der neuen funktionsfähigen Hybride zu analysieren. Die Hybride sind ungiftige Variationen des Genclusters und die Forscher:innen konnten so alle relevanten Teile der Biosynthese untersuchen.
„Dieser Durchbruch zeigt, wie wichtig interdisziplinäre Zusammenarbeit für die Antibiotika-Forschung ist. Unsere Fähigkeit, die Biosynthese von Odilorhabdin vollständig zu entschlüsseln, ist ein bedeutender Schritt in Richtung einer biotechnologischen Produktion. Diese soll es uns erlauben, unseren Wirkstoffkandidaten kosteneffizient und in großen Mengen herzustellen – ein wichtiger Meilenstein auf dem Weg hin zu einer potenziellen Anwendung“, betont Prof. Rolf Müller, geschäftsführender Direktor des HIPS und Leiter der Abteilung Mikrobielle Naturstoffe.
Das Team zeigte auch, dass Odilorhabdin zunächst als sogenanntes Pro-Drug produziert wird. Eine inaktive Vorstufe wird erst nach dem Transport aus der Zelle in das aktive Antibiotikum gespalten. Dadurch wäre es in Zukunft mithilfe des NPRS-Engineering möglich, zahlreiche Varianten herzustellen, die als Vertreter dieser neuen Antibiotikaklasse ein breites Spektrum antimikrobieller Wirkungen ermöglichen könnten.
OriginalPubliKation
Leonard Präve, Carsten E. Seyfert, Kenan A. J. Bozhüyük, Emilie Racine, Rolf Müller, Helge B. Bode. Investigation of the Odilorhabdin Biosynthetic Gene Cluster Using NRPS Engineering. L. Präve, C. E. Seyfert, K. A. J. Bozhüyük, E. Racine, R. Müller, H. B. Bode, Angew. Chem. Int. Ed. 2024, 63, e202406389. DOI: 10.1002/anie.202406389

![[Translate to German:] Alexandra K. Kiemer, Simon Both, Martin Empting](/fileadmin/HIPS/__processed__/c/6/csm_Kiemer_Both_Empting_7700535100.jpg)

















![[Translate to English:] Illustration](/fileadmin/HIPS/__processed__/b/6/csm_WebNews_DataLeakage_53fd0ef4a5.png)

































![[Translate to German:] [Translate to German:]](/fileadmin/HIPS/__processed__/c/9/csm_HZI_wiss_hemmhof_mik_001_611abc3df4.jpg)




![[Translate to German:] [Translate to German:]](/fileadmin/HIPS/__processed__/1/b/csm_Andreas_Keller_2023_org_029c5088c1.jpg)

![[Translate to German:] [Translate to German:]](/fileadmin/HIPS/__processed__/b/3/csm_AufDiePlaetze_WID-8615_4ee837e55b.jpg)

![[Translate to German:] Künstliche Intelligenz unterstützt die Entdeckung von Arzneimitteln aus Naturstoffen](/fileadmin/HIOH/News/AI_in_NP_Drug_Discovery_AdobeStock.jpg)
































![[Translate to Deutsch:] [Translate to Deutsch:]](/fileadmin/HIPS/__processed__/2/b/csm_HZI_wiss_pseudomonas_cpi_hzi_001_62730ae12d.jpg)

















